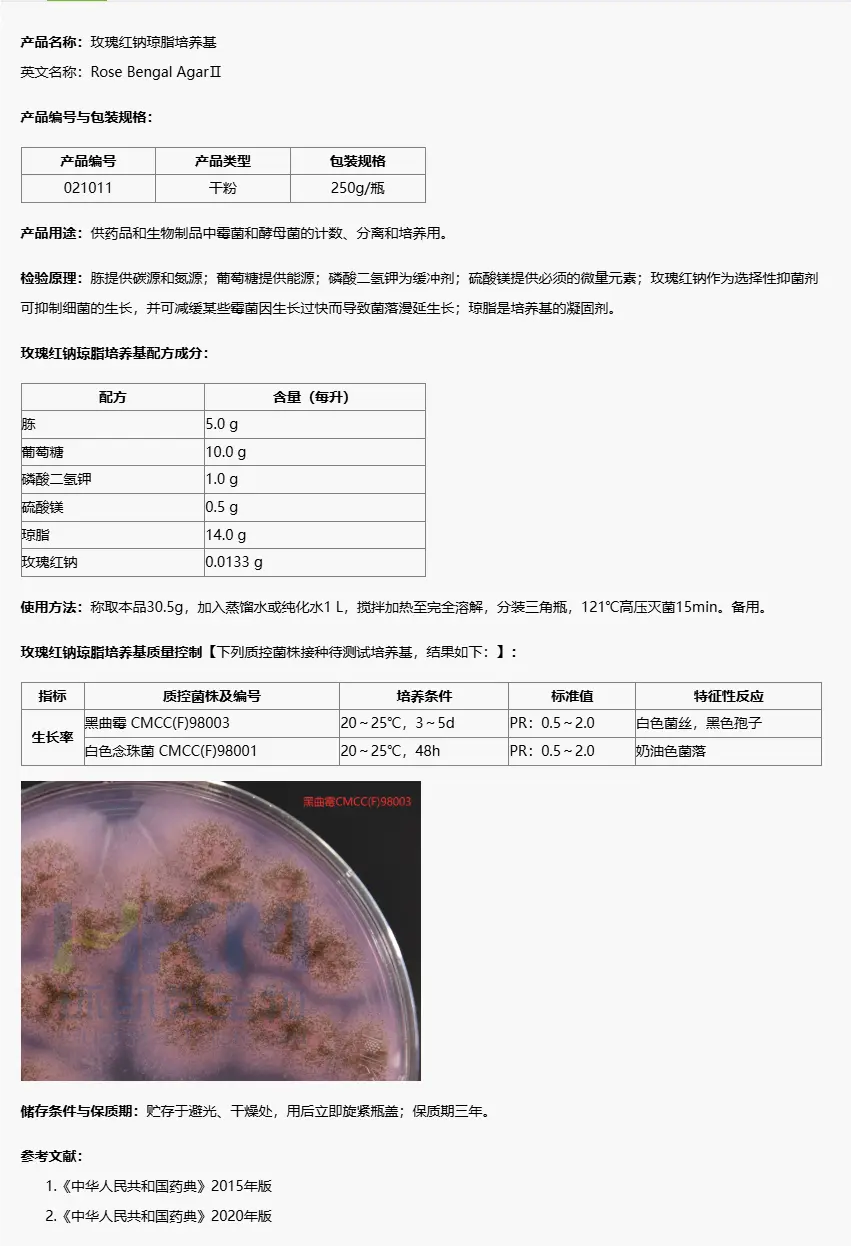
021011 玫瑰红钠琼脂培养基(中国药典) 250g/瓶

商品详细
说明书
微生物图册
行业应用
相关论文
产品名称:玫瑰红钠琼脂平板
英文名称:Rose Bengal Agar Plate
产品编号与包装规格:
| 产品编号 | 产品类型 | 包装规格 |
|---|---|---|
| 024088 | 即用型成品平板 | 90mm×20个/盒 |
产品用途:供药品和生物制品中霉菌和酵母菌的计数、分离和培养用。
成 分:胨、葡萄糖、磷酸二氢钾、硫酸镁、琼脂、玫瑰红纳、蒸馏水(最终pH:6.7±0.2)。
菌落特征:大部分霉菌为菌丝白色、产孢子、表面毛糙,底部粉红色的菌落;酵母菌为圆形光滑的菌落。
注意事项:储存温度需保持恒定,请尽量选择接近使用环境的温度存放,避免温差过大;如存放于冰箱中,不能靠近冰箱冷凝管和风扇直吹位置,以防培养基冻融或萎缩。
储 存:2~25℃,避光保存。
更多产品资料详见 同类干粉培养基:021011 玫瑰红钠琼脂培养基(中国药典) 250g/瓶。⬇️
玫瑰红钠琼脂平板 相关成品培养基产品[用于真菌(霉菌、酵母、食用菌)检测]:
| 产品名称 | 产品货号(类型) | 规格 | 产品说明及用途 |
| 孟加拉红(虎红)琼脂平板 | 021010B(成品平板) | 90mm×20个/盒 | 供霉菌和酵母菌的计数、分离、培养用(GB、SN、化妆品卫生规范) |
| 念珠菌显色培养基平板 | CRM010P1(成品平板) | 90mm×20个/盒 | 用于念珠菌特别是白色念珠菌的选择性分离和初步鉴别(WS) |
| 酵母浸出粉胨葡萄糖琼脂(YPD)平板 | 021100B(成品平板) | 90mm×20个/盒 | 用于酵母菌的培养,及供药品和生物制品中含王浆和蜂蜜的液体制剂酵母菌数测定用 |
| 沙氏琼脂斜面培养基 | CP0480(成品斜面) | 8mL/支 | 用于真菌的分离培养,还用于一次性使用卫生用品真菌菌落总数检测(GB) |
| 沙氏琼脂培养基平板 | CP0170(成品平板) | 90mm×20个/盒 | |
| 沙氏液体培养基(成品瓶装) | CP1091P1(成品瓶装) | 50ml×40瓶/箱 | 用于真菌的分离培养,还用于一次性使用卫生用品真菌定性检测(GB) |
| 沙氏葡萄糖琼脂(SDA)平板 | C21098B1(成品平板) | 90mm×20个/盒 | 用于霉菌和酵母菌培养及总数计数(ChP、ISO、EP、USP、美国FDA、WS) |
| 沙氏葡萄糖琼脂(SDA)斜面培养基 | C21098G1(成品斜面) | 10mL×20支/盒 | |
| 沙氏葡萄糖肉汤(SDB)培养基(瓶装) | CP1096P1(成品瓶装) | 100mL×40瓶/箱 | 用于霉菌和酵母菌培养(ChP、ISO、EP、USP、美国FDA) |
| 沙氏葡萄糖液体(SDB)培养基(管装) | CP1096G1(成品管装) | 10mL/支 | |
| 马铃薯葡萄糖琼脂(PDA)平板 | CP0010(成品平板) | 90mm×20个/盒 | 供霉菌和酵母菌计数及分离培养(ChP) |
| 马铃薯葡萄糖琼脂(PDA)斜面培养基 | CP0120(成品斜面) | 7mL×20支/盒 |
